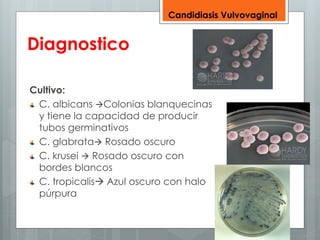
Diagnostico 
Cultivo: 
Candidiasis Vulvovaginal 
C. albicans Colonias blanquecinas 
y tiene la capacidad de producir 
tubos germinativos 
C. glabrata Rosado oscuro 
C. krusei  Rosado oscuro con 
bordes blancos 
C. tropicalis Azul oscuro con halo 
púrpura

Este documento resume las principales enfermedades vaginales, incluyendo infecciones como la vaginosis bacteriana, candidiasis y tricomoniasis. Describe los síntomas, diagnóstico y tratamiento de cada una. También cubre temas como neoplasias benignas, precancerosas y cancerosas de la vagina, siendo el carcinoma escamoso el tipo más común de cáncer vaginal.